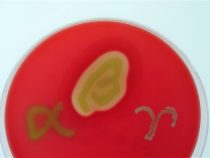

Améby vo vodovode
Výplachy nosa môžu zmierniť prekrvenie nosových dutín. Použitie nesprávnej vody však môže spôsobiť infekciu smrteľnými amébami. Vedci z amerického Centra pre kontrolu a prevenciu chorôb (CDC) v časopise Emerging Infectious Diseases uviedli, že výplach dutín nesterilizovanou vodou z vodovodu môže ľudí vystaviť amébam Acanthamoeba a… pokračuj